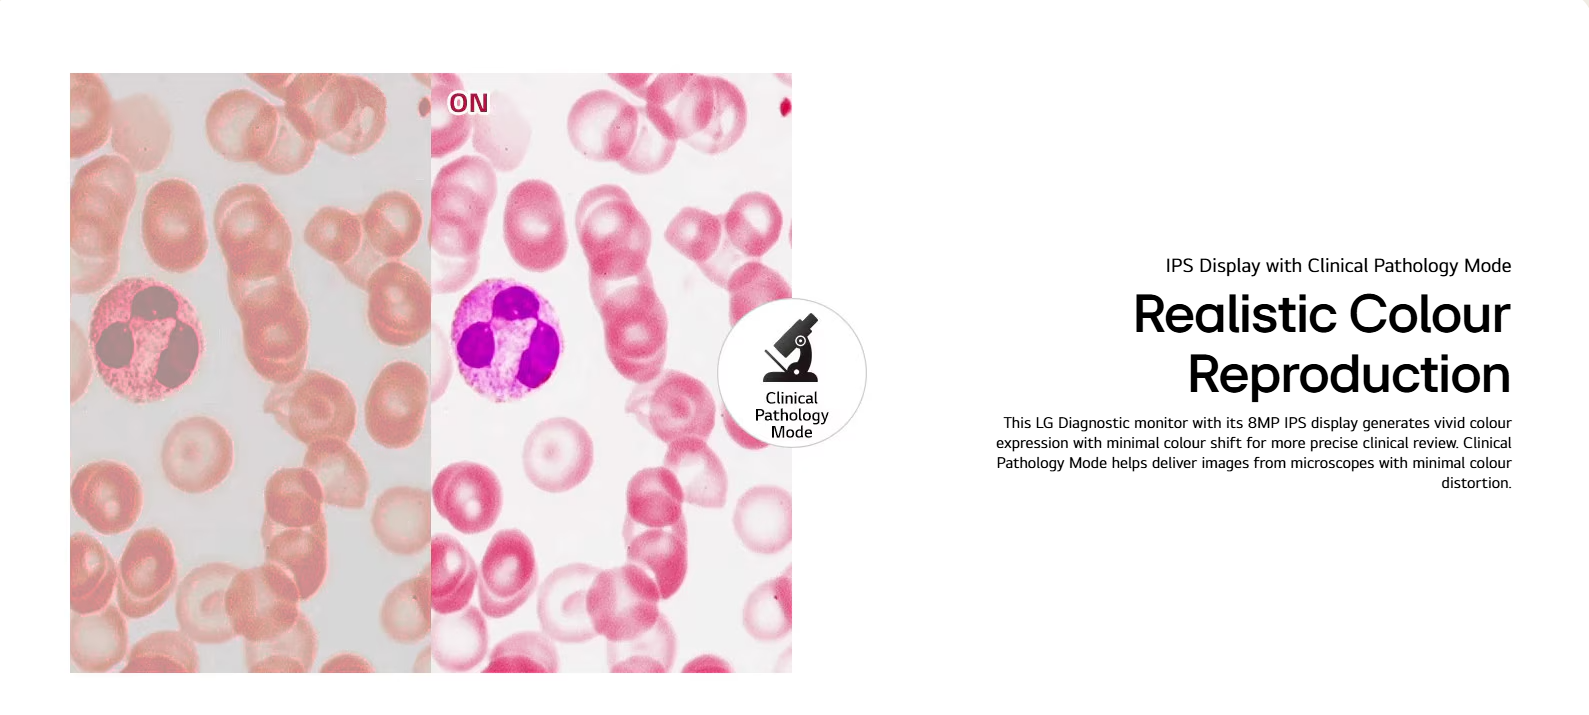

×
This stock info gives you an outline of whether a product on our webstore is available to purchase or not.
Stock Availability:
In Stock: Stock is available and ready to ship.
Available to Click & Collect from MediaForm warehouse: Stock is available for customer to pick-up from either our Sydney, Brisbane or Melbourne warehouse.
SYDNEY PICK-UP HOURS: Monday to Friday, 10am to 2pm
BRISBANE PICK-UP HOURS: Monday to Friday, 9am to 4pm
MELBOURNE PICK-UP HOURS: Temporarily Unavailable
Available to Ship from Supplier Warehouse: Stock is available to ship to customer from our Supplier warehouse but not available to pick-up.
Call us for ETA: Stock is unavailable in MediaForm or supplier warehouses. Product may be on back order (contact us for ETA date) or has been discontinued.
Please understand we do our best to have stock availablity up to date on our webstore but there could be discrepancy at times due to our inventory data not being real-time.